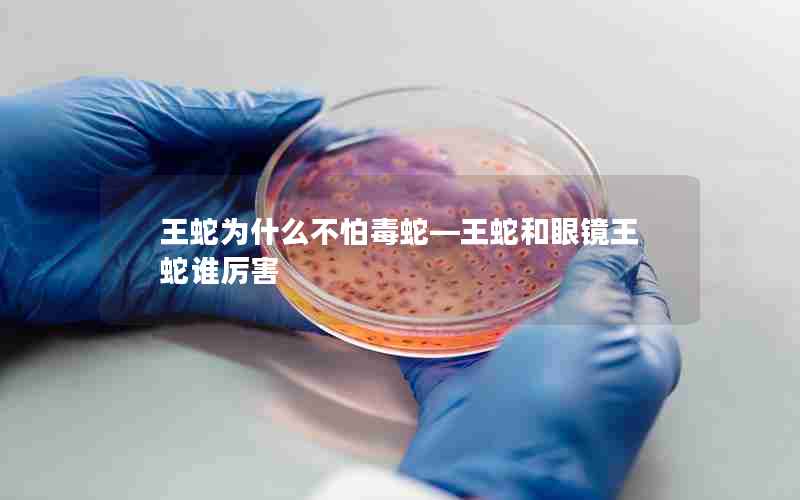
王蛇为什么不怕毒蛇—王蛇和眼镜王蛇谁厉害

摘要:鳄鱼和蟒蛇,都是地球上众多危险的野生动物之一,它们拥有强大的生存能力和独特的生态角色。我们将探讨鳄鱼和蟒蛇之间的差异,以及老鹰是否敢抓眼镜王蛇这一问题。 一、鳄鱼 vs. 蟒蛇 鳄鱼...
鳄鱼和蟒蛇,都是地球上众多危险的野生动物之一,它们拥有强大的生存能力和独特的生态角色。我们将探讨鳄鱼和蟒蛇之间的差异,以及老鹰是否敢抓眼镜王蛇这一问题。

一、鳄鱼 vs. 蟒蛇
鳄鱼和蟒蛇是两种截然不同的爬行动物,它们在生活习性、外貌和生态位上存在明显的区别。
鳄鱼
鳄鱼是一种半水生爬行动物,它们通常栖息在沼泽、湖泊和河流中。鳄鱼的外貌特征包括坚硬的鳞片、强壮的尾巴和短而强壮的四肢,这使它们在水中游动得很快。鳄鱼以肉食为主食,捕食鱼类、鸟类和其他小型动物。它们拥有锋利的牙齿和强大的咬合力,是危险的掠食者。
蟒蛇
蟒蛇则是一种大型的蛇类,通常生活在热带和亚热带地区的森林、草原和沼泽地带。蟒蛇的特点是长而粗壮的身体,通常呈深色斑纹,具有优秀的潜伏能力。它们属于扼杀型蛇类,通过缠绕和扼杀猎物来捕食。蟒蛇的牙齿较短,不具备毒液,但它们可以通过强大的肌肉和扼杀技巧来制服猎物。
二、老鹰敢抓眼镜王蛇吗?
老鹰是一种具有强大爪子和尖嘴的猛禽,它们以捕食小型哺乳动物、鸟类和爬行动物为生。在自然界中,老鹰通常会捕食较小的猎物,而眼镜王蛇是一种相对较小的蛇类,通常生活在树林和草地中。虽然老鹰有能力抓住眼镜王蛇,但是否敢这么做则取决于多种因素。
老鹰会选择捕食那些相对容易捕获的猎物,以最小的风险获得最大的回报。眼镜王蛇通常有一种能够模仿眼睛的斑点,这种视觉欺骗可能会让老鹰认为眼镜王蛇是一种更大的猎物,从而减少捕食的兴趣。
老鹰也会考虑到潜在的风险。眼镜王蛇虽然不是有毒蛇,但它们可以通过咬合来自卫,尤其是在受到威胁时。老鹰可能会权衡食物价值和潜在的伤害风险,从而决定是否抓眼镜王蛇。
老鹰理论上敢抓眼镜王蛇,但它们会慎重考虑食物选择,并尽量避免不必要的风险。老鹰通常会选择更容易捕获的猎物,以确保自己的生存和成功捕食。
在鳄鱼和蟒蛇的比较中,我们了解到这两种动物在外貌和生活习性上存在显著差异。鳄鱼是水生爬行动物,以水中猎食为主,而